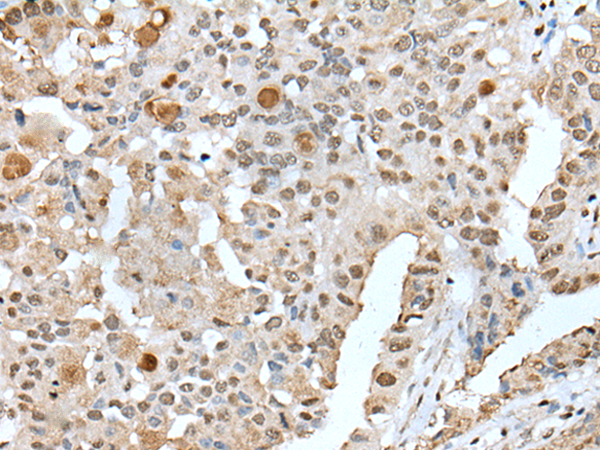

中文名稱: 兔抗ZNF300多克隆抗體
|
Background: |
The protein encoded by this gene is a C2H2-type zinc finger DNA binding protein and likely transcriptional regulator. The function of this protein is not yet known. Three transcript variants encoding different isoforms have been found for this gene. |
|
Applications: |
ELISA, IHC |
|
Name of antibody: |
ZNF300 |
|
Immunogen: |
Fusion protein of human ZNF300 |
|
Full name: |
zinc finger protein 300 |
|
SwissProt: |
Q96RE9 |
|
ELISA Recommended dilution: |
5000-10000 |
|
IHC positive control: |
Human esophagus cancer and human liver cancer |
|
IHC Recommend dilution: |
25-100 |

購物車
購物車 幫助
幫助
 021-54845833/15800441009
021-54845833/15800441009
